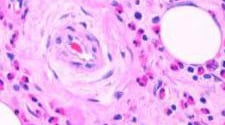
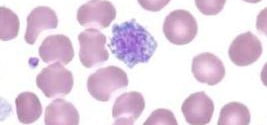
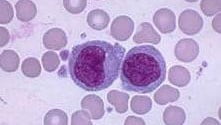
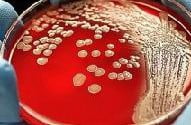

Гемоглобин — входящий в состав эритроцитов крови сложный железосодержащий белок.
Читать »Анализы и диагностика
Расшифровка анализов, что означают те или иные показатели. Диагностика заболеваний по результатам исследований.
Почему в крови гематокрит понижен, что это значит?
Гематокрит — показатель, который определяет содержание красных клеток крови (эритроцитов) в её общем объёме.
Читать »Почему в крови базофилы понижены, о чем это говорит?
Базофилы — клетки крови, образование которых осуществляется в костном мозге, затем они выходят в кровь, циркулируя в ней несколько часов, и далее направляются в ткани, где пребывают на протяжении 8-12 суток.
Читать »Почему в крови гематокрит повышен, что это значит?
Показатель уровня содержания эритроцитов, лейкоцитов и тромбоцитов на весь объем крови в организме называется гематокритом.
Читать »Почему в крови базофилы повышены, о чем это говорит?
Наиболее малочисленной группой лейкоцитов являются базофилы, выполняющие множество функций в человеческом организме.
Читать »Почему в крови эозинофилы понижены, о чем это говорит?
Эзинофилы — это кровяные клетки, которые относятся к лейкоцитам и выполняют крайне важную функцию защиты человеческого организма.
Читать »Почему в крови эозинофилы повышены, о чем это говорит?
Эозинофилы — одна из групп лейкоцитов (белоснежных кровяных клеток). Они относятся к нейтрофильному ряду, но отличаются от нейтрофилов некими особенностями. Они немного крупнее. Ядра у их содержат наименьшее число частей (обычно 2-3).
Читать »Почему в крови моноциты понижены, о чем это говорит?
Моноциты представляют собой группу клеток, относящихся к лейкоцитам.
Читать »Почему нейтрофилы в крови понижены, о чем это говорит?
Нейтрофилы являются самой большой группой лейкоцитов, которые обеспечивают защиту организма от множества инфекций.
Читать »Почему в крови моноциты повышены, о чем это говорит?
Моноциты — зрелые, крупные лейкоциты, содержащие всего одно ядро. Данные клетки являются одними из наиболее активных фагоцитов, находящихся в периферической крови.
Читать »Почему нейтрофилы повышены у взрослого, о чем это говорит?
Нейтрофилами называется самая многочисленная часть лейкоцитов, чьей задачей является защита человеческого организма от самых разных инфекций. Образуются они в костном мозге.
Читать »Почему лимфоциты в крови понижены, о чем это говорит?
Лимфоциты — важные клеточные структуры иммунной системы, относящиеся к группе агранулоцитов. Они обеспечивают основной клеточный и гуморальный иммунитет, регулируют работу других элементов лейкоцитарного комплекса.
Читать »Почему эритроциты в крови повышены, что это значит?
Эритроциты — красные клетки крови, которые синтезируются красным костным мозгом и выполняют транспортную функцию, так как способны переносить кислород из легких ко всем органам и тканям и забирать отработанный углекислый газ обратно к легким.
Читать »Почему тромбоциты в крови повышены, что это значит?
Тромбоциты представляют собой бесцветные и плоские тельца, которые продуцируются в красном костном мозге и отвечают за свертываемость крови. С их помощью и останавливается кровотечение.
Читать »Почему АЛТ повышен, что это значит?
Аланинаминотрансфераза (АЛТ) и аспартатаминотрансфераза (АСТ) представляют собой ферменты, которые являются активными участниками обмена аминокислот. Они способны находиться в клетках почек, печени, сердечных мышц и иных органов.
Читать »Почему тромбоциты в крови понижены, что это значит?
Тромбоцитами являются определенные красные кровяные клеточки, которые полностью отвечают за быстрое и своевременное свертывание крови.
Читать »Что означает повышенное СОЭ в крови
Скорость оседания эритроцитов (СОЭ) — это показатель, который и на сегодняшний день имеет важное значение для диагностики организма.
Читать »Почему повышены лимфоциты в крови, что это значит?
Один из важнейших компонентов иммунной системы — лимфоциты, они являют собой отдельную группу лейкоцитов.
Читать »Норма СОЭ в крови у мужчин, женщин и детей: таблица
Тест на скорость оседания эритроцитов (СОЭ) принят в медицине всего мира как обязательный при проведении общего анализа крови.
Читать »Почему повышен билирубин в крови, и что это значит?
Билирубин является желто-зеленым пигментом, который образуется при распаде гемоглобина. В организме человека он содержится в крови и в желчи. За обмен и превышение нормы билирубина отвечает непосредственно печень.
Читать »Как проводят анализ методом ПЦР: описание процедуры
Полимеразная цепная реакция известна уже 30 лет. Ее широко используют во многих областях, начиная с археологии и заканчивая генетикой.
Читать »Анализ мочи на бак посев: как сдавать и что показывает?
Анализ мочи на бак посев (бактериологический посев мочи) — лабораторное исследование мочи, направленное на выявление возбудителя и на определение уровня бактериурии при занесении инфекции в мочеполовую систему.
Читать »Расшифровка результатов общего анализа мочи у взрослых: таблица
Общий анализ мочи — комплексное лабораторное исследование, которое выявляет ряд физических и химических характеристик субстанции, на его основе можно поставить ряд диагнозов.
Читать »В моче обнаружены бактерии, что это значит?
У здорового человека не должно быть в анализе мочи бактерий. Если же бактериологическое исследование мочи обнаруживает их, это состояние называется бактериурией и требует лечения у специалиста — уролога.
Читать »Почему лейкоциты в крови понижены, и что это значит?
Низкий уровень лейкоцитов в крови называется лейкопенией. Так как лейкоциты в организме отвечают за защитные функции, то их низкий уровень приводит к снижению иммунитета.
Читать »Почему лейкоциты в крови повышены: причины и лечение
Повышение белых кровяных телец в крови (лейкоцитов) называется лейкоцитозом.
Читать »Почему в анализах обнаруживается слизь в моче?
Биохимический состав мочи является основным индикатором нашего физиологического состояния и здоровья. Состав мочи включает 90% воды и 10% сухих органических веществ, которые имеют сложную химическую структуру.
Читать »Повышенные эритроциты в моче: причины и лечение
Исследования мочи выполняются при диагностике и лечении многих видов заболеваний, а также при проведении плановых медицинских осмотров.
Читать »Почему белок в моче повышен
Одним из отклонений в общем анализе мочи является присутствие повышенного уровня белка.
Читать »Какие причины повышенных лейкоцитов в мазке у женщин?
Лейкоциты в женском организме выполняют защитную функцию. Их присутствие свидетельствует о том, что местный иммунитет находится в норме.
Читать »